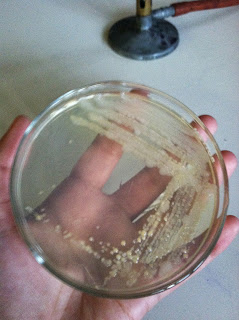

When we removed our stock bacteria of sample S from the incubator we found the bacteria had grown in the same pattern as our first slanted agar plate and looked the same, so we were able to successfully transfer the bacteria.
Next we wanted to examine the bacteria more closely so put it on a microscope slide. Using the inoculating loop we got a bead of bacteria from our working culture (not the stock culture) and mixed it on the slide with a small drop of distilled water.
We waited for the slide to dry and then passed our slide through the flame of the Bunsen burner three times to heat fix our smear to the slide.
After this we proceeded to do a gram stain on our slide. We cover the slide with crystal violet for 20 seconds, then rinsed it off.
Next we covered the smear with gram's iodine for one minute, then rinsed it off.
Holding the slide at a 45 degree angle we dropped EtOH on the slide until the color from the stains stopped running. Immediately after we rinsed the slide and then covered the slide with safranin for one minute, and rinsed off the excess stain after.
To completely dry the slide we blotted it with bibulous paper, and then it was ready to be observed under the microscope. We put oil on the slide so that we could view the bacteria using the oil immersion lens. The oil is necessary because it has a refractive index that is the same as glass. Light can bend in air, so with the oil there, less light is lost and one is able to see their specimen more clearly.
By using the oil immersion lens we were able to see our sample more clearly, and this is what we observed!
We found that our culture S was gram negative and the shape was long skinny rods. If you look closely you can even see some in the midst of binary fission. (they are the ones that look like long chains because they are multiplying to be many short rods)